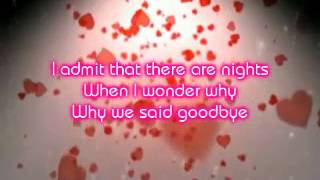
Sarah Dawn Finer - I remember Love (Lyrics)

Song info
"I Remember Love" Videos
Lyrics
I can see it in your eyes
I can see it in your face
I could feel it when we touched
It used to mean so much
But now it's gone away
We were young and dreams were new
And every word we said was true
Any mountain we could climb
You made me feel alive
The first time in my life
Yes I remember love
So beautiful
Now I know, my heart is breakable
Yes I remember love
The true meaning of
I remember, I remember love
Though the years have come and gone
Oh, and by now we've both moved on
I admit that there are nights
When I wonder why
Why we said goodbye
'Cause I remember love
So beautiful
Now I know my heart is breakable
Yes I remember love
The true meaning of
I remember, I remember love
Oh, I've been losing faith each time I fall
But I still believe love conquers all
'Cause I remember love
(So beautiful)
(Now I know)Now I know my heart is breakable
Cause I remember love
The true meaning of
(I remember, I remember love)
Yes, I remember, I remember love
(Now I know)Now I know my heart is breakable
When we see your face as I hear your voice
I remember, I remember love
- 0 Bản dịch
Hiện tại chưa có lời dịch cho bài hát này. Bạn hãy là người đầu tiên chia sẻ lời dịch cho bài hát này nhé !
Đăng lời dịchAlbums has song "I Remember Love"

Singles
12 songs
- I Remember Love 2010
- Moving On 2016
- Kärleksvisan 2010
- Is Anybody There 2015
- Nu Vet Du Hur Det Känns 2012
- Christmas Time Is Here 2018
- Maybe This Christmas 2018
- Have Yourself a Merry Little Christmas 2018
- The Christmas Song 2018
- Have Yourself a Merry Litte Christmas 2018
- Maybe this is Christmas 2018
- I'll Be Home for Christmas 2018

Singles
12 songs
- I Remember Love 2010
- Moving On 2016
- Kärleksvisan 2010
- Is Anybody There 2015
- Nu Vet Du Hur Det Känns 2012
- Christmas Time Is Here 2018
- Maybe This Christmas 2018
- Have Yourself a Merry Little Christmas 2018
- The Christmas Song 2018
- Have Yourself a Merry Litte Christmas 2018
- Maybe this is Christmas 2018
- I'll Be Home for Christmas 2018

Recent comments